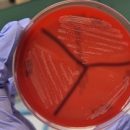

Main Menu
- Chi siamo
- Aree Tematiche
- Sicurezza alimentare
- Sanità animale
- Protezione / Benessere
- Anagrafi degli animali
- Farmaco e antibioticoresistenza
- Igiene urbana
- Fauna selvatica ed esotica
- Ambiente e biodiversità
- Acquacoltura e prodotti ittici
- Spreco alimentare
- Emergenze non epidemiche
- Sottoprodotti di origine animale
- Politiche sanitarie
- One Health
- Attualità SIMeVeP
- Gruppi di Lavoro
- Acquacoltura e prodotti della pesca
- Affari europei
- Ambiente e cambiamenti climatici
- Cooperazione decentrata
- Diritto e legislazione veterinaria
- Farmaco veterinario e Antibioticoresistenza
- Fauna selvatica
- Filiere fragili e produzioni locali
- Igiene urbana e comportamento animale
- Prodotti dell’alveare e sicurezza alimentare
- Protezione animale alla macellazione
- Rapporti e strategie di comunicazione con i consumatori
- Rapporti internazionali
- Sanità, epidemiologia e ricerca in apicoltura
- World food, novel food
- Progetti
- Pubblicazioni
- Formazione